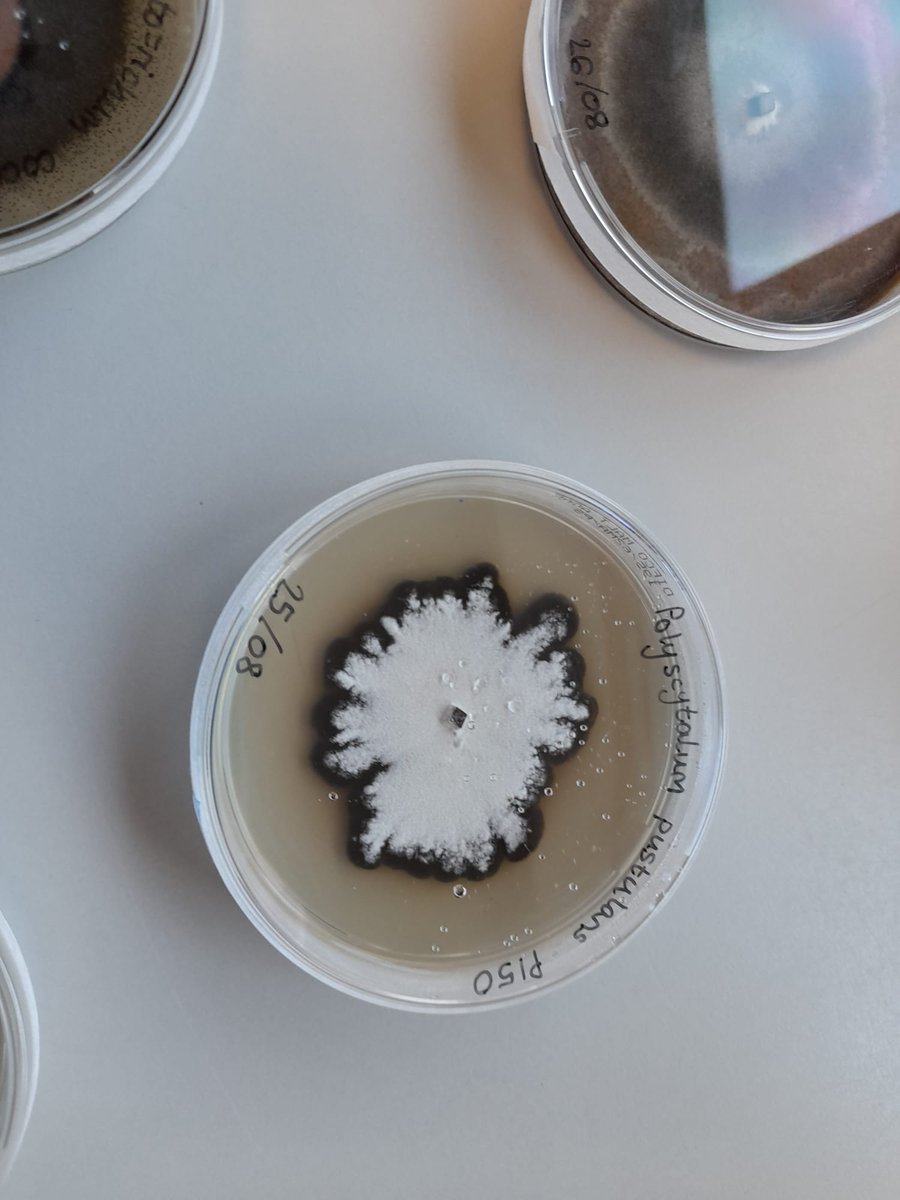
Branston Seed tweet media

@Branston are sponsoring a guide dog this year. We were treated yesterday to a visit from the Guide Dogs for the Blind Association along with two Labrador retrievers (both in training). Staff were also given the chance to propose a name for the Branston puppy!

English